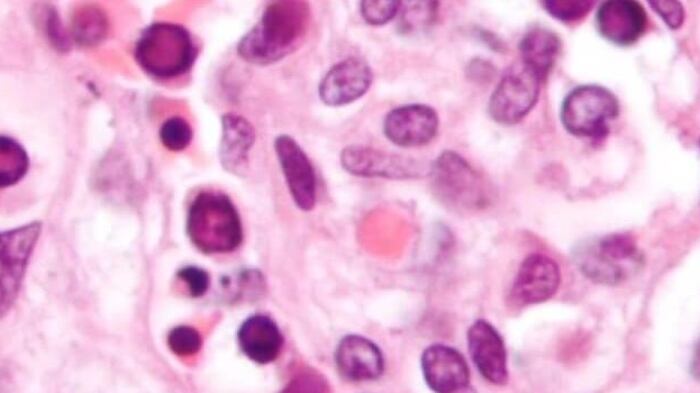

ATHENS, Ga. — An outbreak of parvo-virus is causing problems at an Athens-Clarke County animal shelter.
The Department of Animal Services confirmed two dogs tested positive for the virus on Monday.
Shelter officials said the puppy area will be closed during this time and some dogs in affected spaces may not be available for adoption.
“Our facility and animal shelters all over the country face the same challenges with animal viruses due to the numbers of stray and community animals that come through them,” says Animal Services Director Kristall Barber. “Most of the time, these viruses are already present in animals prior to their arrival at the shelter, but symptoms and positive results don’t occur until after an incubation period and often not until they’ve been here a few days.”
[DOWNLOAD: Free WSB-TV News app for alerts as news breaks]
The department will not accept any owner-surrendered dogs until July 23.
For more information about Animal Services and the Adoption Center, visit www.accgov.com/animalservices or call 706-613-3540.
Parvo is a highly contagious virus that affects all dogs, particularly unvaccinated dogs and puppies.
The shelter will continue dog intakes and cat adoptions and intakes.
TRENDING STORIES:
- Elderly man dies after being trapped in metro Atlanta apartment fire
- 20-year-old missing after swimming with friends at Lake Lanier
- Teen arrested for kidnapping, child molestation in Athens after series of hit-and-run crashes
[SIGN UP: WSB-TV Daily Headlines Newsletter]
IN OTHER NEWS:
©2024 Cox Media Group